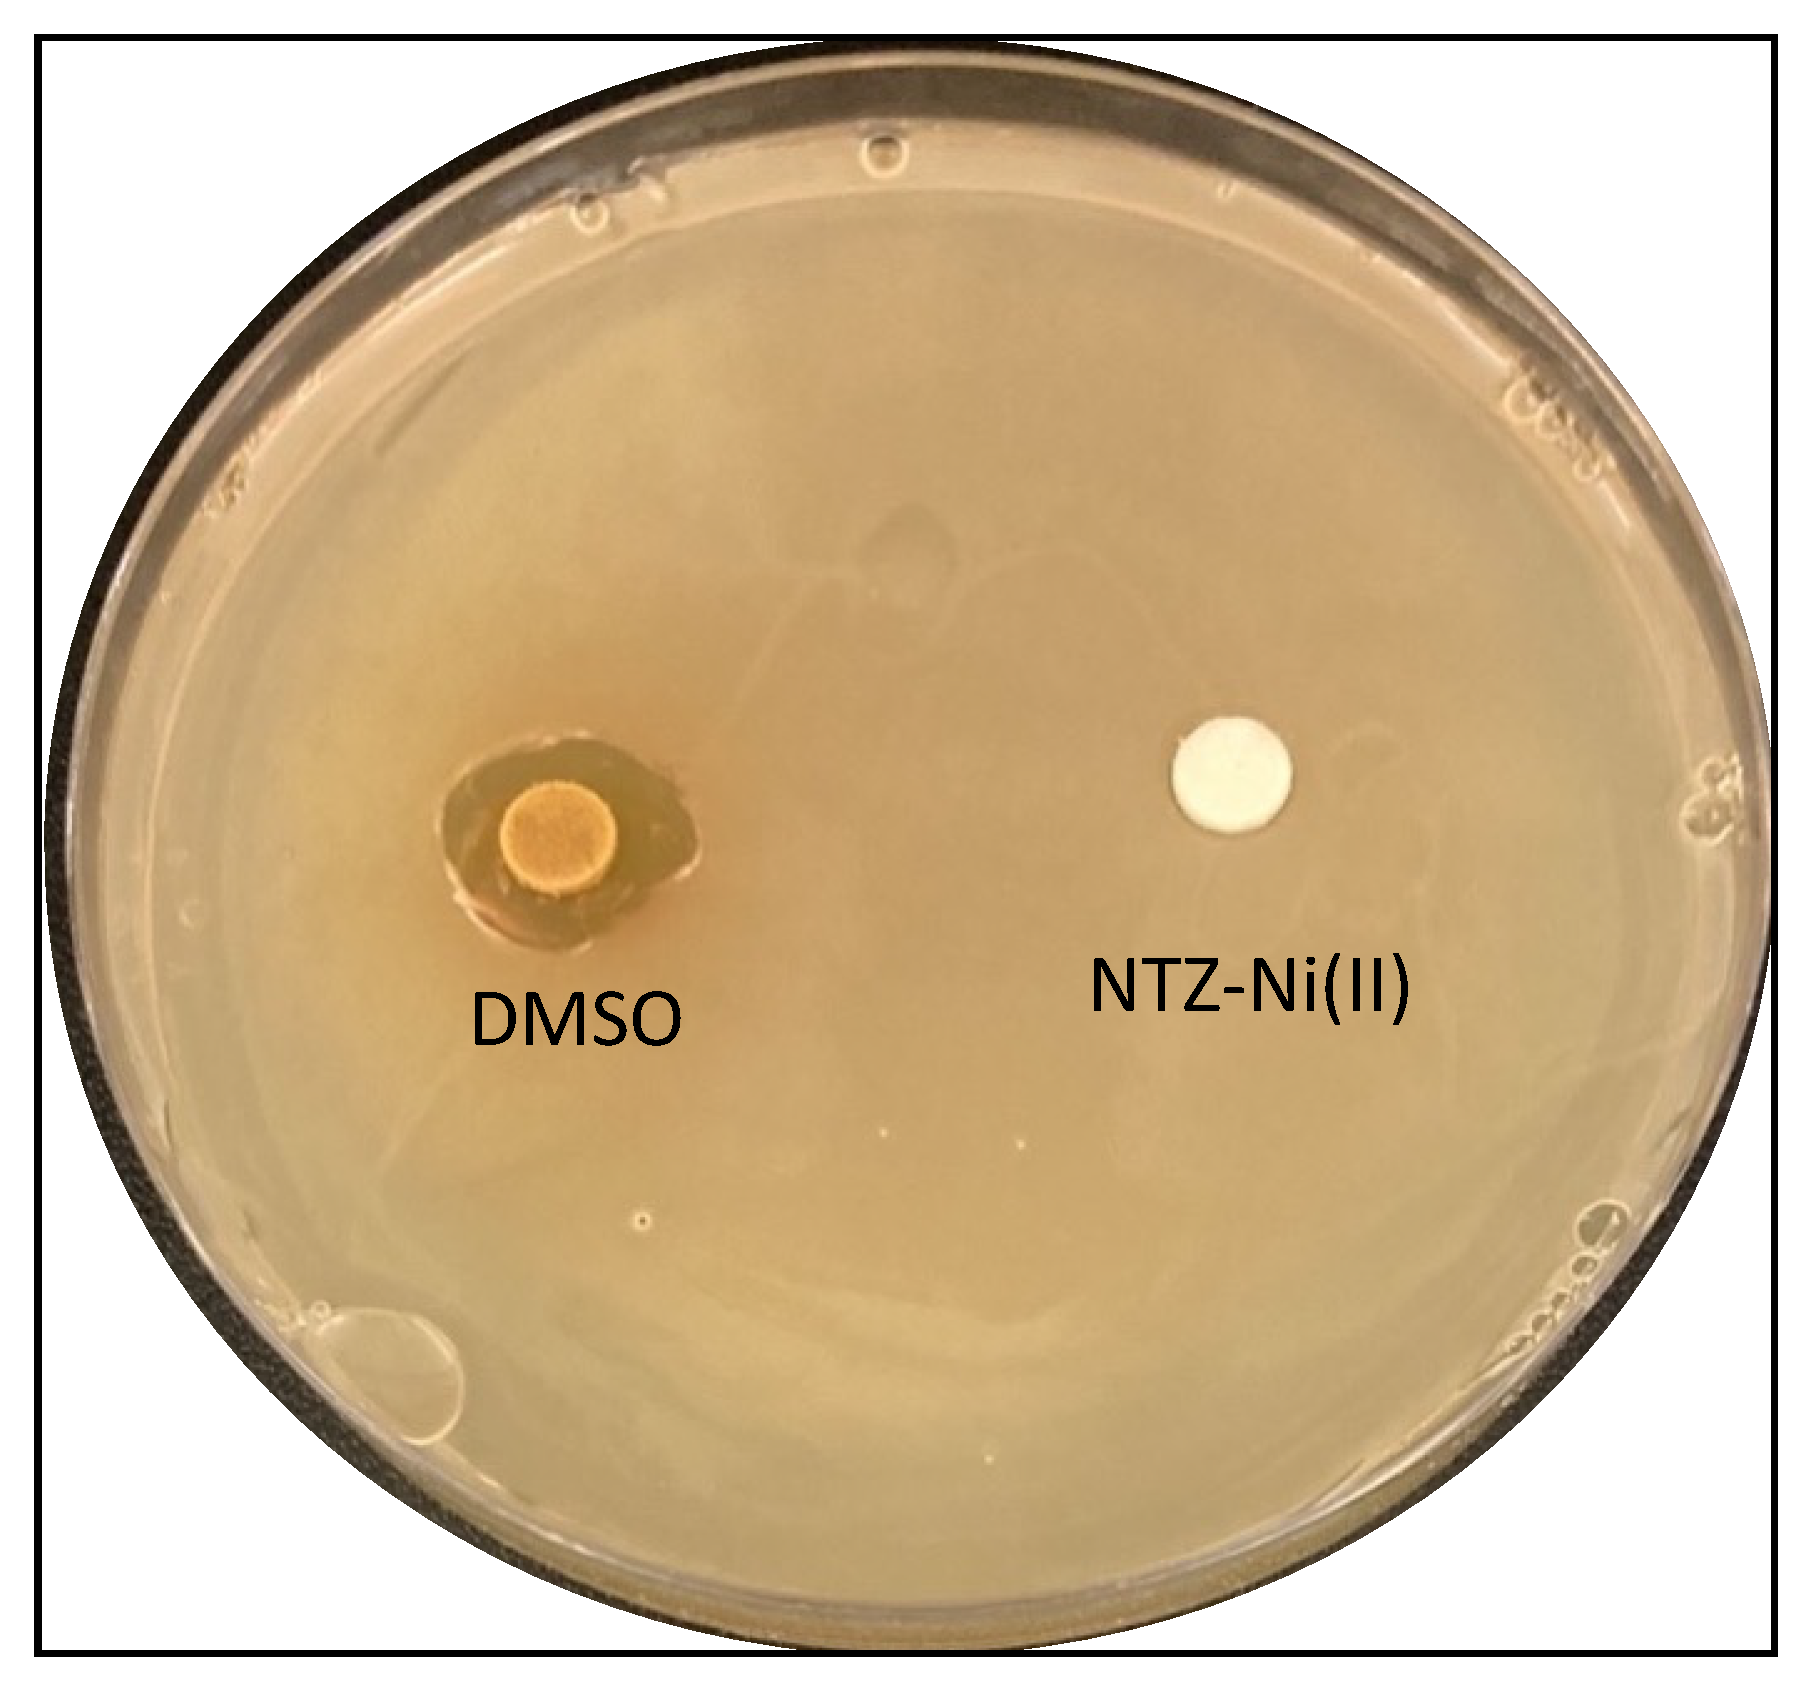
Molecules 28 06126 g010

Investigating the Biological Potency of Nitazoxanide-Based Cu(II), Ni(II) and Zn(II) Complexes Synthesis, Characterization and Anti-COVID-19, Antioxidant, Antibacterial and Anticancer Activities
Abstract
:1. Introduction
2. Results and Discussion
2.1. General Chemical and Physical Characterization
2.2. Computational Studies
2.3. Biological Activities
2.3.1. Absorption and Fluorescence Studies with Protein (HSA)
2.3.2. Absorption DNA Binding Studies
2.3.3. In Silico Study of NTZ Complexes COVID-19 Binding
2.3.4. Antioxidant Assay
2.3.5. Antibacterial Activity
2.3.6. In Vitro Antiproliferative Activity
3. Experimental
3.1. Chemicals and Instruments
3.2. Synthesis of Metal Complexes
3.3. Theoretical Calculations
3.3.1. Optimization Procedure
3.3.2. Molecular Docking Platforms
3.4. In Vitro Binding of Complexes to Biological Molecules
3.5. Assay for Antioxidant Properties
3.6. Antibacterial Activity
3.7. Cytotoxicity Assessment (MTT Assay)
4. Conclusions
Supplementary Materials
Author Contributions
Funding
Data Availability Statement
Acknowledgments
Conflicts of Interest
Sample Availability
References
- Rusanov, D.A.; Zou, J.; Babak, M.V. Biological Properties of Transition Metal Complexes with Metformin and Its Analogues. Pharmaceuticals 2022, 15, 453. [Google Scholar] [CrossRef]
- Babak, M.V.; Ahn, D. Modulation of intracellular copper levels as the mechanism of action of anticancer copper complexes: Clinical relevance. Biomedicines 2021, 9, 852. [Google Scholar] [CrossRef] [PubMed]
- Müller, S.; Versini, A.; Sindikubwabo, F.; Belthier, G.; Niyomchon, S.; Pannequin, J.; Grimaud, L.; Cañeque, T.; Rodriguez, R. Metformin reveals a mitochondrial copper addiction of mesenchymal cancer cells. PLoS ONE 2018, 13, e0206764. [Google Scholar]
- Fox, C.L., Jr. Zinc Sulfadiazine and its Use in the Treatment of Burns. U.S. Patent US4049802A, 20 September 1977. [Google Scholar]
- Carr, H.S.; Wlodkowski, T.J.; Rosenkranz, H.S. Silver sulfadiazine: In Vitro antibacterial activity. Antimicrob. Agents Chemother. 1973, 4, 585–587. [Google Scholar] [CrossRef] [PubMed]
- Sharfalddin, A.A.; Emwas, A.-H.M.; Jaremko, M.; Abdulala, M.A. Practical and Computational studies of Bivalence Metal Complexes of Sulfaclozine and Biological Studies. Front. Chem. 2021, 9, 644691. [Google Scholar] [CrossRef]
- Anderson, V.R.; Curran, M.P. Nitazoxanide. Drugs 2007, 67, 1947–1967. [Google Scholar] [CrossRef]
- Rossignol, J.-F. Nitazoxanide: A first-in-class broad-spectrum antiviral agent. Antivir. Res. 2014, 110, 94–103. [Google Scholar] [CrossRef]
- White, A.C., Jr. Nitazoxanide: A new broad spectrum antiparasitic agent. Expert Rev. Anti-Infect. Ther. 2004, 2, 43–49. [Google Scholar] [CrossRef]
- Fan-Minogue, H.; Bodapati, S.; Solow-Cordero, D.; Fan, A.; Paulmurugan, R.; Massoud, T.F.; Felsher, D.W.; Gambhir, S.S. A c-Myc activation sensor-based high-throughput drug screening identifies an antineoplastic effect of nitazoxanide. Mol. Cancer Ther. 2013, 12, 1896–1905. [Google Scholar] [CrossRef]
- Di Santo, N.; Ehrisman, J. A functional perspective of nitazoxanide as a potential anticancer drug. Mutat. Res. Fundam. Mol. Mech. Mutagen. 2014, 768, 16–21. [Google Scholar] [CrossRef]
- Mansour, A.M. Spectroscopic, DFT, magnetic and biological activity evaluation of Pd (II), Pt (II) and Ru (III) complexes of Nitazoxanide. Inorg. Chim. Acta 2016, 453, 697–703. [Google Scholar] [CrossRef]
- Mansour, A.M. Effect of metal complex formation on the antibacterial activity of nitazoxanide: Spectroscopic and density functional theory calculations. Appl. Organomet. Chem. 2018, 32, e4023. [Google Scholar] [CrossRef]
- Sharfalddin, A.A.; Alyounis, E.I.M.; Emwas, A.-H.; Jaremko, M. Biological efficacy of novel metal complexes of Nitazoxanide: Synthesis, characterization, anti-COVID-19, antioxidant, antibacterial and anticancer activity studies. J. Mol. Liq. 2022, 368, 120808. [Google Scholar] [CrossRef]
- Tayde, D.; Sarwade, S.S.; Jadhav, W.; Khade, B. A study on the complexes of transition metals with nitazoxanide. Sch. Res. Libr. Arch. Appl. Sci. Res. 2015, 7, 28–35. [Google Scholar]
- Sarwade, S.; Jadhav, W.; Khade, B.; Tayde, D. A mononuclear complex of silver (I) with nitazoxanide. Chem. Sin. 2015, 6, 1–4. [Google Scholar]
- Sharfalddin, A.A.; Emwas, A.H.; Jaremko, M.; Hussien, M.A. Synthesis and Theoretical Calculations of Metal–Antibiotic Chelation with Thiamphenicol; In vitro DNA and HSA Binding, Molecular Docking, and Cytotoxic Studies. New J. Chem. 2021, 45, 9598–9613. [Google Scholar] [CrossRef]
- Orfão, R.B.; Alves, J.; Bartoloni, F.H. Spectroscopic Studies on the Interaction of Metallic Ions with an Imidazolyl-Phenolic System. J. Fluoresc. 2016, 26, 1373–1380. [Google Scholar] [CrossRef]
- El-desoky, H.S.; Ghoneim, M.M.; Abdel-Galeil, M.M. A direct spectrophotometric method for determination of antiparasitic drug nitazoxanide in a bulk form and pharmaceutical formulation. Chem. Anal. 2009, 54, 1065. [Google Scholar]
- Alghrably, M.; Dudek, D.; Emwas, A.-H.; Jaremko, Ł.; Jaremko, M.; Rowińska-Żyrek, M. Copper (II) and amylin analogues: A complicated relationship. Inorg. Chem. 2020, 59, 2527–2535. [Google Scholar] [CrossRef]
- Sharfalddin, A.A.; Hussien, M.A. Bivalence Metal Complexes of Antithyroid Drug Carbimazole; Synthesis, Characterization, Computational simulation, and Biological Studies. J. Mol. Struct. 2020, 1228, 129725. [Google Scholar] [CrossRef]
- Garribba, E.; Micera, G. The determination of the geometry of Cu (II) complexes: An EPR spectroscopy experiment. J. Chem. Educ. 2006, 83, 1229. [Google Scholar] [CrossRef]
- Kivelson, D.; Neiman, R. ESR studies on the bonding in copper complexes. J. Chem. Phys. 1961, 35, 149–155. [Google Scholar] [CrossRef]
- Alshehri, N.S.; Sharfalddin, A.A.; Domyati, D.; Basaleh, A.S.; Hussien, M.A. Experiment versus theory of copper (II) complexes based imidazole derivatives as anti-cancer agents. J. Indian Chem. Soc. 2022, 99, 100692. [Google Scholar] [CrossRef]
- Emwas, A.H.M.; Al-Talla, Z.A.; Guo, X.; Al-Ghamdi, S.; Al-Masri, H.T. Utilizing NMR and EPR spectroscopy to probe the role of copper in prion diseases. Magn. Reson. Chem. 2013, 51, 255–268. [Google Scholar] [CrossRef]
- Sharfalddin, A.A.; Emwas, A.-H.; Jaremko, M.; Hussien, M.A. Complexation of uranyl (UO2) 2+ with bidentate ligands: XRD, spectroscopic, computational, and biological studies. PLoS ONE 2021, 16, e0256186. [Google Scholar] [CrossRef]
- Alomari, F.Y.; Sharfalddin, A.A.; Abdellattif, M.H.; Domyati, D.; Basaleh, A.S.; Hussien, M.A. QSAR Modeling, Molecular Docking and Cytotoxic Evaluation for Novel Oxidovanadium(IV) Complexes as Colon Anticancer Agents. Molecules 2022, 27, 649. [Google Scholar] [CrossRef]
- Howsaui, H.B.; Sharfalddin, A.A.; Abdellattif, M.H.; Basaleh, A.S.; Hussien, M.A. Synthesis, Spectroscopic Characterization and Biological Studies of Mn(II), Cu(II), Ni(II), Co(II) and Zn(II) Complexes with New Schiff Base of 2-((Pyrazine-2-ylimino) methyl) phenol. Appl. Sci. 2021, 11, 9067. [Google Scholar] [CrossRef]
- Basaleh, A.S.; Alomari, F.Y.; Sharfalddin, A.A.; Al-Radadi, N.S.; Domyati, D.; Hussien, M.A. Theoretical Investigation by DFT and Molecular Docking of Synthesized Oxidovanadium (IV)-Based Imidazole Drug Complexes as Promising Anticancer Agents. Molecules 2022, 27, 2796. [Google Scholar] [CrossRef]
- Chen, Z.; Wu, Y.; Zhang, Q.; Zhang, Y. Biological properties of a benzothiazole-based mononuclear platinum (II) complex as a potential anticancer agent. J. Coord. Chem. 2020, 73, 1817–1832. [Google Scholar] [CrossRef]
- Tian, J.; Liu, X.; Zhao, Y.; Zhao, S. Studies on the interaction between tetraphenylporphyrin compounds and bovine serum albumin. Lumin. J. Biol. Chem. Lumin. 2007, 22, 446–454. [Google Scholar] [CrossRef]
- Sirajuddin, M.; Ali, S.; Badshah, A. Drug–DNA interactions and their study by UV–Visible, fluorescence spectroscopies and cyclic voltametry. J. Photochem. Photobiol. B Biol. 2013, 124, 1–19. [Google Scholar] [CrossRef]
- Shahabadi, N.; Kashanian, S.; Khosravi, M.; Mahdavi, M. Multispectroscopic DNA interaction studies of a water-soluble nickel (II) complex containing different dinitrogen aromatic ligands. Transit. Met. Chem. 2010, 35, 699–705. [Google Scholar] [CrossRef]
- Ashwini Kumar, K.; Reddy, K.L.; Vidhisha, S.; Satyanarayana, S. Synthesis, characterization and DNA binding and photocleavage studies of [Ru (bpy) 2BDPPZ] 2+, [Ru (dmb) 2BDPPZ] 2+ and [Ru (phen) 2BDPPZ] 2+ complexes and their antimicrobial activity. Appl. Organomet. Chem. 2009, 23, 409–420. [Google Scholar] [CrossRef]
- Mahmoud, D.B.; Shitu, Z.; Mostafa, A. Drug repurposing of nitazoxanide: Can it be an effective therapy for COVID-19? J. Genet. Eng. Biotechnol. 2020, 18, 35. [Google Scholar] [CrossRef] [PubMed]
- Lokhande, A.S.; Devarajan, P.V. A review on possible mechanistic insights of Nitazoxanide for repurposing in COVID-19. Eur. J. Pharmacol. 2021, 891, 173748. [Google Scholar] [CrossRef] [PubMed]
- Basaleh, A.S.; Howsaui, H.B.; Sharfalddin, A.A.; Hussien, M.A. Substitution effect on new Schiff base ligand in complexation with some divalent Metal ion; Synthesis, Characterization, DFT and Cytotoxicity Studies. Results Chem. 2022, 4, 100445. [Google Scholar] [CrossRef]
- Alshaikh, N.E.; Zaki, M.; Sharfalddin, A.A.; Al-Radadi, N.S.; Hussien, M.A.; Hassan, W.M. Synthesis, structural characterization, DNA/HSA binding, molecular docking and anticancer studies of some D-Luciferin complexes. Arab. J. Chem. 2023, 16, 104845. [Google Scholar] [CrossRef]
- Yang, H.; Yang, M.; Ding, Y.; Liu, Y.; Lou, Z.; Zhou, Z.; Sun, L.; Mo, L.; Ye, S.; Pang, H. The crystal structures of severe acute respiratory syndrome virus main protease and its complex with an inhibitor. Proc. Natl. Acad. Sci. USA 2003, 100, 13190–13195. [Google Scholar] [CrossRef]
- Jadid, N.; Hidayati, D.; Hartanti, S.R.; Arraniry, B.A.; Rachman, R.Y.; Wikanta, W. Antioxidant Activities of Different Solvent Extracts of Piper Retrofractum Vahl. Using DPPH Assay. AIP Conf. Proc. 2017, 1854, 020019. [Google Scholar]
- Rodríguez-Arce, E.; Saldías, M. Antioxidant properties of flavonoid metal complexes and their potential inclusion in the development of novel strategies for the treatment against neurodegenerative diseases. Biomed. Pharmacother. 2021, 143, 112236. [Google Scholar] [CrossRef]
- Cooper, G.M. Cells as Experimental Models; The National Center for Biotechnology Information: Sunderland, MA, USA, 2000. [Google Scholar]
- Prabhakaran, P.; Hassiotou, F.; Blancafort, P.; Filgueira, L. Cisplatin induces differentiation of breast cancer cells. Front. Oncol. 2013, 3, 134. [Google Scholar] [CrossRef]
- Precomputed Vibrational Scaling Factors. 2018. Available online: https://cccbdb.nist.gov/vibscalejust.asp (accessed on 16 July 2023).
- Sood, S.; Maddiboyina, B.; Rawat, P.; Garg, A.K.; Foudah, A.I.; Alam, A.; Aldawsari, H.M.; Riadi, Y.; Singh, S.; Kesharwani, P. Enhancing the solubility of nitazoxanide with solid dispersions technique: Formulation, evaluation, and cytotoxicity study. J. Biomater. Sci. Polym. Ed. 2020, 32, 477–487. [Google Scholar] [CrossRef]
- Zhang, H.; Shi, Y.; Wang, H. Solubility determination of nitazoxanide in twelve organic solvents from T = 273.15 to 313.15 K. J. Chem. Eng. Data 2020, 65, 3645–3651. [Google Scholar] [CrossRef]
- Frisch, M.; Trucks, G.; Schlegel, H.B.; Scuseria, G.E.; Robb, M.A.; Cheeseman, J.R.; Scalmani, G.; Barone, V.; Mennucci, B.; Petersson, G. Gaussian 09, Revision d. 01; Gaussian Inc.: Wallingford, CT, USA, 2009; Volume 201. [Google Scholar]
- Hay, P.J.; Wadt, W.R. Ab initio effective core potentials for molecular calculations. Potentials for K to Au including the outermost core orbitals. J. Chem. Phys. 1985, 82, 299–310. [Google Scholar] [CrossRef]
- Re, R.; Pellegrini, N.; Proteggente, A.; Pannala, A.; Yang, M.; Rice-Evans, C. Antioxidant activity applying an improved ABTS radical cation decolorization assay. Free. Radic. Biol. Med. 1999, 26, 1231. [Google Scholar] [CrossRef]
- Al-Younis, I.; Moosa, B.; Kwiatkowski, M.; Jaworski, K.; Wong, A.; Gehring, C. Functional crypto-adenylate cyclases operate in complex plant proteins. Front. Plant Sci. 2021, 12, 711749. [Google Scholar] [CrossRef]
- Moosa, B.A.; Sagar, S.; Li, S.; Esau, L.; Kaur, M.; Khashab, N.M. Synthesis and anticancer evaluation of spermatinamine analogues. Bioorg. Med. Chem. Lett. 2016, 26, 1629–1632. [Google Scholar] [CrossRef]

| Structure | Evacuum (kJ/mol) | EDMSO (kJ/mol) | |
|---|---|---|---|
| Keto |  | −5,767,354.7 | −5,767,509.4 |
| Enol |  | −5,763,872.0 | −5,763,859.1 |
| Complex | Step | Temperature | Weight Loos Found (Calc) | Assignments | Total Mass Loss/% Found (Calc) | Final Residue Found (Calc) |
|---|---|---|---|---|---|---|
| [Zn(NTZ)2Cl2] | 1st | 69–200 | 28 (28.3) | 2NO+2Cl+2CO+C2H6 | 76 (77.3) | ZnO 24 (23.2) |
| 2nd | 255–700 | 48 (49) | 2C2H4+CN+3NO+2H2O+2SO2 | |||
| [Ni(NTZ)2Cl2]·H2O | 1st | 25–229 | 29.8 (30.8) | 2NO+2Cl+CO+H2O | 78.5 (79.9) | NiO 22 (21.4) |
| 2nd | 320–790 | 48.7 (49.1) | 4CN+2SO2+5C2H4 | |||
| [Cu(NTZ)2Cl2]·H2O | 1st | 25–309 | 28.8 (30) | 2NO+2Cl+CO+H2O | 76.9 (78) | CuO 23 (22.6) |
| 2nd | 390–770 | 47.8 (48.1) | 4CN+2SO2+5C2H4 |
| Compound | HUMO | LUMO | ∆E | x | η | σ | Pi | S | ω | ΔNmax |
|---|---|---|---|---|---|---|---|---|---|---|
| NTZ-Cu(II) | −6.33 | −3.86 | 2.47 | 5.07 | 1.24 | 0.73 | −5.07 | 0.62 | 9.40 | 3.71 |
| NTZ-Ni(II) | −6.43 | −3.70 | 2.73 | 5.10 | 1.37 | 0.81 | −5.10 | 0.68 | 2.55 | 4.12 |
| NTZ-Zn(II) | −6.27 | −3.64 | 2.63 | 4.96 | 1.32 | 0.76 | −4.96 | 0.66 | 2.48 | 3.76 |
| Complex | 2D Image | 3D Image |
|---|---|---|
| NTZ |  |  |
| NTZ-Cu(II) |  |  |
| NTZ-Ni(II) |  |  |
 | ||
| IC50 | Ascorbic Acid | NTZ-Free | NTZ-Zn(II) | NTZ-Ni(II) | NTZ-Cu(II) |
|---|---|---|---|---|---|
| (μg/mL) | 32.00 ± 0.05 | 725.89 ± 0.10 | 89.35 ± 0.05 | 53.45 ± 0.50 | 106.92 ± 0.30 |
| Compound | Inhibition Zones (mm) | Activity Index (%) | Minimum Inhibition Concentration (MIC, μM) |
|---|---|---|---|
| Free NTZ | 8 | 24.24 | 105 |
| NTZ-Cu(II) | 22 | 66.66 | 6.5 |
| NTZ-Ni(II) | 26 | 78.79 | 6 |
| NTZ-Zn(II) | 14 | 42.42 | 13.5 |
| Ampicillin | 33 | 100 | 3.5 |
| Compound | MCF-7 | HELA | HEK293 | ||
|---|---|---|---|---|---|
| µg/mL | µM | µg/mL | µM | µg/mL | |
| NTZ-free | 62 ± 4 | 202 | 78 ± 10 | 254 | 1050 ± 10 |
| NTZ-Cu(II) | 24.5 ± 2 | 78.19 | 21.5 ± 9 | 70 | 809 ± 6 |
| NTZ-Ni(II) | 56.0 ± 3 | 182 | 42.0 ± 5 | 136.8 | 920 ± 8 |
| NTZ-Zn(II) | 31.4 ± 3 | 102.3 | 39.0 ± 5 | 127 | 815 ± 8 |
| Cisplatin | 2.43 [44] | 17.2 [37] | - | ||
Disclaimer/Publisher’s Note: The statements, opinions and data contained in all publications are solely those of the individual author(s) and contributor(s) and not of MDPI and/or the editor(s). MDPI and/or the editor(s) disclaim responsibility for any injury to people or property resulting from any ideas, methods, instructions or products referred to in the content. |
© 2023 by the authors. Licensee MDPI, Basel, Switzerland. This article is an open access article distributed under the terms and conditions of the Creative Commons Attribution (CC BY) license (https://creativecommons.org/licenses/by/4.0/).
Share and Cite
Sharfalddin, A.A.; Al-Younis, I.M.; Emwas, A.-H.; Jaremko, M. Investigating the Biological Potency of Nitazoxanide-Based Cu(II), Ni(II) and Zn(II) Complexes Synthesis, Characterization and Anti-COVID-19, Antioxidant, Antibacterial and Anticancer Activities. Molecules 2023, 28, 6126. https://doi.org/10.3390/molecules28166126
Sharfalddin AA, Al-Younis IM, Emwas A-H, Jaremko M. Investigating the Biological Potency of Nitazoxanide-Based Cu(II), Ni(II) and Zn(II) Complexes Synthesis, Characterization and Anti-COVID-19, Antioxidant, Antibacterial and Anticancer Activities. Molecules. 2023; 28(16):6126. https://doi.org/10.3390/molecules28166126
Chicago/Turabian StyleSharfalddin, Abeer A., Inas M. Al-Younis, Abdul-Hamid Emwas, and Mariusz Jaremko. 2023. "Investigating the Biological Potency of Nitazoxanide-Based Cu(II), Ni(II) and Zn(II) Complexes Synthesis, Characterization and Anti-COVID-19, Antioxidant, Antibacterial and Anticancer Activities" Molecules 28, no. 16: 6126. https://doi.org/10.3390/molecules28166126
APA StyleSharfalddin, A. A., Al-Younis, I. M., Emwas, A.-H., & Jaremko, M. (2023). Investigating the Biological Potency of Nitazoxanide-Based Cu(II), Ni(II) and Zn(II) Complexes Synthesis, Characterization and Anti-COVID-19, Antioxidant, Antibacterial and Anticancer Activities. Molecules, 28(16), 6126. https://doi.org/10.3390/molecules28166126






